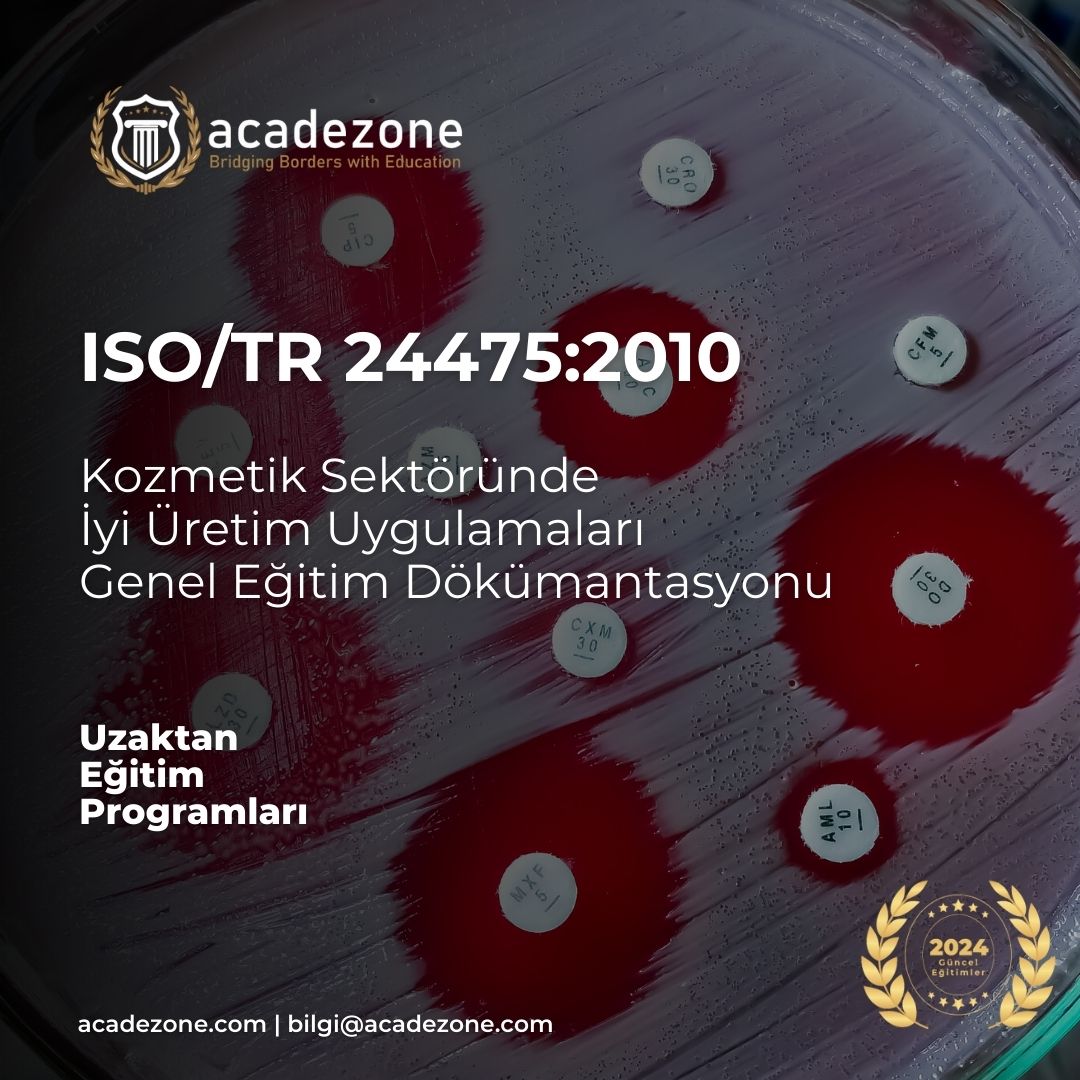
ISO/TR 24475:2010 - Kozmetik Sektöründe GMP - Genel Dökümantasyon
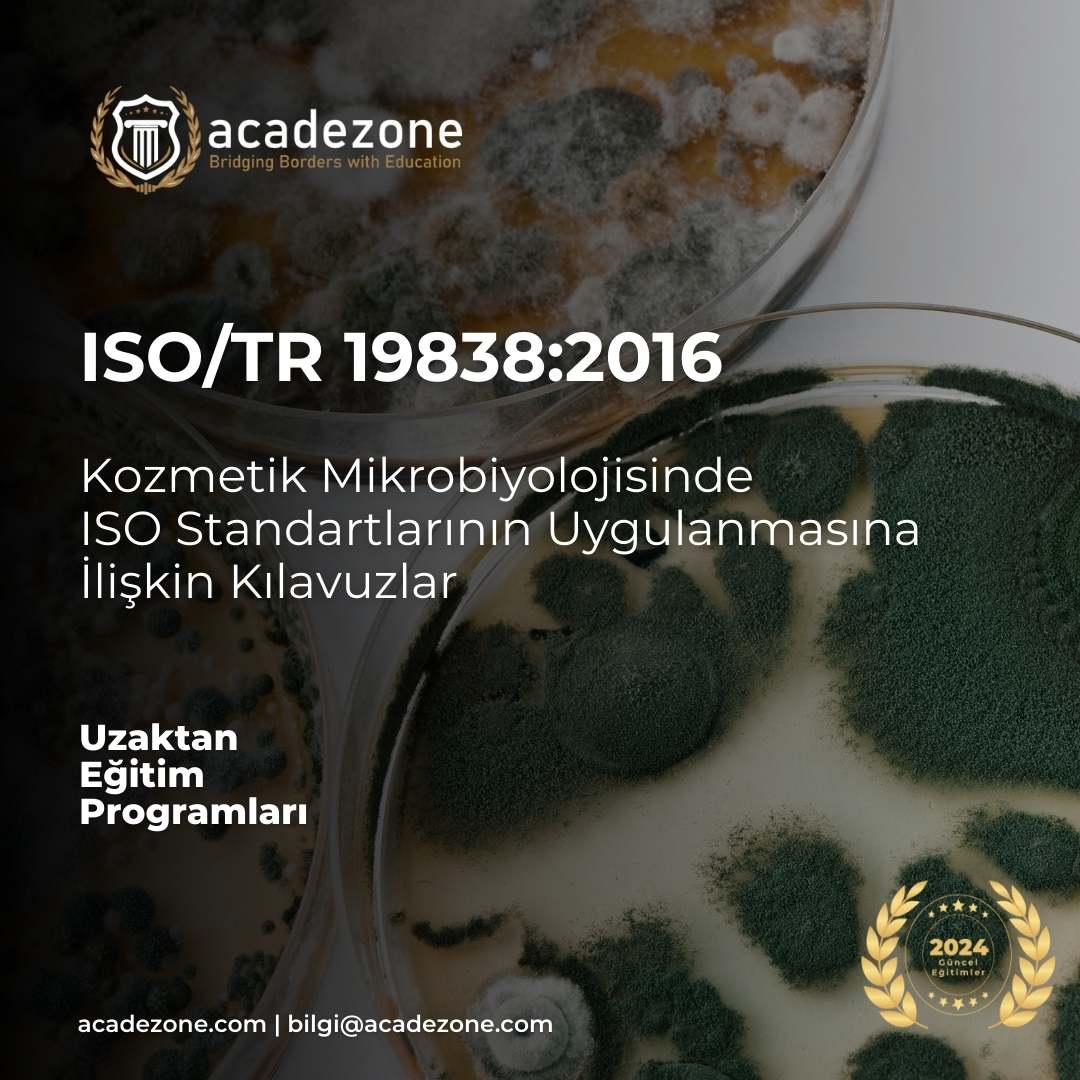
ISO/TR 19838:2016 - Kozmetik Mikrobiyolojisinde ISO Standartlarının Uygulanmasına İlişkin Kılavuzlar

Büyük Güncelleme Duyurusu


Acadezone





Eğitmen biyografisi mevcut değil!
ISO 17273:2024 Su Ürünleri Tesislerinde Atık Yönetim Gereklilikleri
içinde ÇevreISO 15347-6:2025 - PS, EPS ve XPS Atık Kalite Gereklilikleri
içinde ÇevreISO 5667‑27:2025 - Mikroplastiklerin Numuneleme Gereklilikleri
içinde ÇevreISO 14064-3 : Sera Gazı Beyanlarının Doğrulama ve Onaylama Gereklilikleri
içinde ÇevreISO 14064-2:2019 Sera Gazı Emisyonlarının Azaltılmasına Yönelik Gereklilikler
içinde ÇevreISO 14064-1 Sera Gazı Hesaplama ve Raporlama Gereklilikleri
içinde ÇevreISO 24511:2024 - Atıksu Yönetimi ve Değerlendirme Gereklilikleri
içinde ÇevreISO 5441 Biorisk Yönetimi
içinde ÇevreISO 15342:2025 - Polistiren (PS) Geri Dönüştürülmüş Malzemelerin Karakterizasyon Gereklilikleri
içinde ÇevreISO 15345 :2025 Polipropilen Geri Dönüştürülmüş Malzemelerin Karakterizasyon Gereklilikleri
içinde ÇevreISO 8680:2020 - Su Güvenliği Planı (WSP)
içinde Çevre15347-4 PET Atık Sınıflandırma ve Geri Dönüşüm Gereklilikleri
içinde Çevre15347-5:2025 - PVC Atık Sınıflandırma Gereklilikleri
içinde ÇevreLaboratuvar Güvenliği
içinde BiyolojiISO 14971:2019: Tıbbi Cihazlarda Risk Yönetim Sistemi
içinde BiyomedikalISO 15347-3:2025 - PP atıkları Kalite Sınıfları Ve Test Yöntemleri
içinde ÇevreISO 15347-1:2024 Sınıflandırılmış Plastik Atıkların Genel Karakterizasyonu
içinde ÇevreISO 15347-2:2025 - PE Bazlı Plastik Atıkların Kalite Gereklilikleri
içinde ÇevreFarmakolojik GMP - İyi Üretim Uygulamaları
içinde BiyolojiEU Annex 1 - İlaç Sektöründe Steril Üretim Gereklilikleri
içinde BiyolojiFDA 21 CFR 820 Kalite Sistem Yönetmelik Eğitimi
içinde EczacilikCAPA - Düzeltici ve Önleyici Faaliyetler
içinde BiyolojiISO 14155:2020 - İnsanlara yönelik Tıbbi Cihazların Klinik Araştırması - İyi Klinik Uygulamaları
içinde BiyomühendislikIn Vitro Diagnostik (IVD) 2017/746/EU Gereklilikleri
içinde BiyomedikalISO 20784:2021-Duyusal Analiz Tüketim Ürünlerinin İddialarının Doğrulanması
içinde GıdaIATF 16949: Otomotiv Kalite Yönetim Sistemi
içinde MuhendislikDeneme - ISO 17516:2014 - Kozmetik Sektöründe Mikrobiyolojik Limitler
içinde BiyolojiNATO AQAP-2110
içinde MuhendislikKlinik Çalışmalarda Uluslararası FDA E8 R1 Eğitimi
içinde EczacilikMDR - EU Tıbbi Cihazlar Yönetmeliği Gereklilikleri
içinde BiyomedikalCXS 181 - Kilo Kontrol Diyetlerinde Kullanılan Formül Gıdalar İçin Standart
içinde BiyolojiCXS72 1981:2023 Bebek Maması ve Bebekler İçin Özel Tıbbi Amaçlı Mamalar Standardı
içinde GıdaISO 17516 - Kozmetik Sektöründe Mikrobiyolojik Limitler
içinde EczacilikUluslararası Veteriner Aşı Teknolojileri ve Uygulamaları
içinde VeterinerlikOECD Principles on GLP
içinde VeterinerlikISO 10993-2 - Hayvan Refahı Gereklilikleri
içinde VeterinerlikDirective 2010/63/EU
içinde VeterinerlikGLP (İyi Laboratuvar Uygulamaları) Eğitimi
içinde BiyolojiCXS 74-1981 - İşlenmiş Tahıl Bazlı Gıda Standardı - Çocuklar ve Bebekler için
içinde BiyolojiISO/TS 30421:2021 IK Yönetimi: İşten Ayrılma ve Çalışan Bağlılığı Metrikleri
içinde İnsan KaynaklariISO 30405:2023 İnsan Kaynakları Yönetimi : İşe Alım Yönergeleri
içinde İnsan KaynaklariISO 30434:2023 İnsan Kaynakları Yönetimi : İşgücü tahsisi
içinde İnsan KaynaklariISO/TS 30427:2021 İnsan Kaynakları Yönetimi Maliyet Metrikleri Kümesi
içinde İnsan KaynaklariISO/TS 30411:2018 İnsan Kaynakları Yönetimi İşe Alım Kalitesi Metriği
içinde İnsan KaynaklariISO/TS 30431:2021:İnsan Kaynakları Yönetimi-Yönetici Ölçüm Kümeleri
içinde İnsan KaynaklariISO/TS 24179:2020 İnsan Kaynakları Yönetimi: İş Sağlığı ve Güvenliği Metrikleri
içinde İnsan KaynaklariCXS 73-1981 - Konserve Bebek Mamaları Standardı
içinde GıdaCXS 87-1981 Çikolata ve Çikolata Ürünleri Standardı
içinde GıdaISO 30415:2021:İnsan Kaynakları Yönetimi:Çeşitlilik ve katılım
içinde İnsan KaynaklariISO 30428:2021 İnsan Kaynakları Yönetimi:Beceri ve Yetenekler Metrik Kümesi
içinde İnsan KaynaklariISO 20399:2022 - Hücre ve Gen Terapileri için Yardımcı Kaynak Yeterliliği Eğitimi
içinde BiyomühendislikDeneme - ISO 15842:2019 - Gıda Maddelerinde Gıda Alerjenlerinin Tespiti
içinde BiyolojiKonfigürasyon Yönetimi
içinde MuhendislikDFMEA - Potansiyel Tasarım Hata Türü Etkileri Analizi
içinde MuhendislikSahte Parçaların Önlenmesi
içinde MuhendislikAS9100:2016 Havacılık & Uzay ve Savunma Sanayinde Kalite Gereklilikleri
içinde MuhendislikAS9102-C FAI - First article inspection
içinde MuhendislikAS9146:2017 Yabancı Madde Hasarı Önleme
içinde MuhendislikISO 30435:2023 - İnsan Kaynakları Yönetim Sistemi - İşgücü Veri Kalitesi
içinde İnsan KaynaklariISO/TS21560:2020 - Doku mühendisliği ürünü tıbbi ürünlere ilişkin genel gereklilikler
içinde BiyolojiISO 7101:2023 Sağlık Kurumlarında Kalite Yönetim Sistemi
içinde Sağlık YönetimiISO 23447:2023 Sağlık Kuruluşu Yönetimi - El Hijyeni Performansı
içinde Sağlık YönetimiISO/TS 30437:2023 İnsan Kaynakları Yönetimi : Öğrenme ve gelişim metrikleri
içinde İnsan KaynaklariISO 9001:2015 - Temel Kalite Yönetim Sistemleri
içinde Üretim MühendisliğiISO 22886:2020 Sağlık Kuruluşu Yönetimi - Terimler
içinde Sağlık YönetimiISO 10993-17:2023 - Tıbbi Cihaz Bileşenlerinin Toksikolojik Risk Değerlendirmesi
içinde BiyomedikalISO 22956:2021 Hasta Odaklı Personel İstihdamı İçin Gereklilikler
içinde Sağlık YönetimiISO 5741:2023 Geçici Tıbbi Tesis Standardı
içinde Sağlık YönetimiISO 30409 İnsan Kaynakları Yönetimi - İşgücü planlaması
içinde İnsan KaynaklariISO 23662:2021 Vejetaryenler veya Veganlar için Uygun Gıdalar ve Gıda İçerikleri ile Etiketleme ve Beyanlara İlişkin Tanımlar ve Teknik Kriterler
içinde GıdaISO 3100:2018 Risk Yönetimi
içinde İnsan KaynaklariISO 20417:2021:Tıbbi Cihazlar Üretici Tarafından Sağlanacak Bilgiler Standartı
içinde BiyomedikalISO 16061:2021:Non-Aktif Cerrahi implantlarla Birlikte Kullanılmak Üzere Aletler
içinde BiyomedikalISO/TS 30407:2017 İnsan Kaynakları Yönetimi: İşe Alım Maliyeti
içinde İnsan KaynaklariISO 30422:2022 İnsan Kaynakları Yönetimi: Öğrenme ve Gelişim
içinde İnsan KaynaklariISO 30408:2016 İnsan Kaynakları Yönetimi: İnsan Yönetimine İlişkin Yönergeler
içinde İnsan KaynaklariISO 23326:2022 İnsan Kaynakları Yönetimi : Çalışan Bağlılığı
içinde İnsan KaynaklariISO/TS 30400:2022 İnsan Kaynakları Yönetimi: Terminoloji
içinde İnsan KaynaklariISO/TR 20831:2017 - İlaç Yönetimi Kavramları ve Tanımları
içinde EczacilikISO 22716 - Kozmetik Sektöründe GMP
içinde EczacilikISO/TS 23357:2023 - Genomik Bilişim
içinde BiyolojiISO/IEC/IEEE 23026:2023 - Sistem ve Yazılım Mühendisliği
içinde BilişimISO/IEC 27032:2023 - Sibergüvenlik - İnternet Güvenliğine İlişkin Yönergeler
içinde BilişimISO/IEC25059:2023 - Sistemler Yazılım Kalite Gereksinimleri ve Değerlendirmesi
içinde BilişimISO/IEC TR 27563:2023 - Yapay Zeka Kullanım Örneklerinde Güvenlik ve Gizlilik
içinde BilişimISO/TR 3242:2022 - Blockchain ve Dağıtılmış Defter Teknolojileri – Kullanım Örnekleri
içinde BilişimISO 45003:2021 - İşyerinde Psikolojik Sağlık ve Güvenlik
içinde PsikolojiISO 10991:2023 : Mikroakışkanlar - Kelime Bilgisi
içinde VeterinerlikISO 17523:2016 - Elektronik Reçete Gereklilikleri
içinde EczacilikISO/IEC22989:2022 - Yapay Zeka Kavramları ve Terminolojisi
içinde BilişimISO 14064-1:2019 - Sera Gazı Emisyonlarının Giderimlerinin Ölçülmesi Raporlanması
içinde ÇevreISO/TS 22692:2020 - Genomik Bilişim - DNA Dizilimi için Kalite Kontrol Ölçümleri
içinde BiyolojiISO 20387:2018 - Biyoteknoloji - Biyobankacılık için Genel Gereksinimler
içinde BiyolojiISO/PAS 7020:2023 - Cerrahi Kapak Protezlerinin Boyutlandırma Parametreleri
içinde BiyomühendislikISO 5840-1:2021 - Kardiyovasküler İmplantlar - Kalp Kapak Protezlerinde Genel Gereksinimler
içinde BiyomühendislikISO 21148:2017 : Kozmetik Mikrobiyolojisi: Ürün Analizi İçin Genel Rehberlik
içinde EczacilikISO/TR 24475:2010 - Kozmetik Sektöründe GMP - Genel Dökümantasyon
içinde EczacilikISO/TR 19838:2016 - Kozmetik Mikrobiyolojisinde ISO Standartlarının Uygulanmasına İlişkin Kılavuzlar
içinde EczacilikISO 22715:2006 - Kozmetik Sektöründe Etiketleme ve Paketleme Kriterleri
içinde EczacilikISO 29621:2017 - Kozmetik Mikrobiyolojisi: Ürün Analizi İçin Genel Rehberlik
içinde EczacilikISO 11930:2019 - Kozmetik Bir Ürünün Antimikrobiyal Korumasının Değerlendirilmesi
içinde EczacilikISO 18385:2016 Adli Biyolojik Materyalin toplanması, saklanması ve analiz edilmesinde DNA kontaminasyonu riskinin en aza indirilmesi
içinde BiyomühendislikFT-IR Fourier Dönüşümlü Kızılötesi
içinde BiyolojiUV-VIS Ultraviyole (UV) Visible (Vis) Spektrofotometre
içinde BiyolojiAnalitik Metot Validasyonu
içinde BiyolojiGC : Gaz Kromatografisi
içinde BiyolojiTS EN ISO/IEC 17025 Deney ve Kalibrasyon Lab. Yeterliliği İçin Genel Şartlar
içinde BiyolojiISO 13485:2016 Tıbbi Cihazlar Kalite Yönetim Sistemi
içinde BiyolojiISO 15189:2022 Tıbbi Laboratuvarlar Kalite ve Yeterlilik İçin Gereklilikler
içinde BiyolojiGDP - İyi Dağıtım Uygulamaları
içinde EczacilikISO 210:2023 - Esansiyel Yağlar Hakkında Genel Gereksinimler
içinde Eczacilik
The instructor doesn't have any articles!
 Faithful User
Öğrenim Sürecinizi Doldurmak Üzeresiniz
Faithful User
Öğrenim Sürecinizi Doldurmak Üzeresiniz
 Expert Vendor
Has 3 to 6 Classes
Expert Vendor
Has 3 to 6 Classes
 Golden Classes
Classes Rating from 4 to 5
Golden Classes
Classes Rating from 4 to 5
 King Seller
Classes Sales from 10 to 20
King Seller
Classes Sales from 10 to 20
 Fantastic Support
Support Rating from 4 to 5
Fantastic Support
Support Rating from 4 to 5

Eğitmen toplantılar için müsait değil...
Mesaj Gönder
LMS Sisteminde Büyük Bir Güncelleme Yapıldı!

Değerli öğrencilerimiz 2025 sonuna doğru plandığımız Yeni LMS öğrenim sistemine erken erişimi açmış bulunmaktayız. Bu nedenle şuanda kullanmış olduğunuz eski LMS sisteminden çıkıp yeni LMS sistemine geçişinizi sağlayabilmemiz için destek talebi açmanızı rica ederiz. Yeni LMS sisteminde, dökümanlarınız , sertifikalarınız ve ilgili tüm kariyer planlamalar ve yeni eklenmiş olan Tools-Kit'ler bulunmaktadır. Geçiş yapıldığında tüm derslerinize tekrardan +1 yıl ve bir kez daha +1 yıl uzatma hakkı tanımaktan mutluluk duyuyoruz. Hali hazırda öğrenciliği biten eski öğrencilerimizde yeni LMS sisteminden yararlanabilirler. Eski LMS sistemimizden yeni LMS'ye geçişte tüm sınav ve sertifikalarınızın sıfırlanacağını ( eğer daha önce oluşturulduysa kullanabilirsiniz ) yeni LMS'de tekrar sınavlara girmeniz gerektiğini unutmamanız gerekir. Yeni sistemde belgenizin oluşturulması için beklemenize gerek bulunmamaktadır. Lütfen Yeni Sisteme Geçiş Bilgilendirmesi butonuna tıklayarak duyuruyu okuyunuz.
.png)
.png)
.png)
.png)
.png)
.png)
.png)
.png)
.png)
.png)
.png)
.png)
.png)
.png)

.png)
.png)
.png)
.jpg)

.png)
.png)

 2017746EU Gereklilikleri.png)

.png)
.png)
.png)
.jpg)
.png)
.png)
.jpg)
.jpg)
.png)
.png)
.png)
.png)
.png)
.png)
.png)
.png)
.png)
.png)
.png)
.png)
.png)
.jpg)
.jpg)
.png)
.png)
.jpg)
.png)





.png)



.jpg)
.png)





.png)




.png)
.png)
.png)
.png)
.png)

.jpg)

.jpg)
.jpg)
.jpg)

.jpg)
.jpg)
.jpg)
.jpg)
.jpg)
.jpg)
.jpg)
.jpg)
